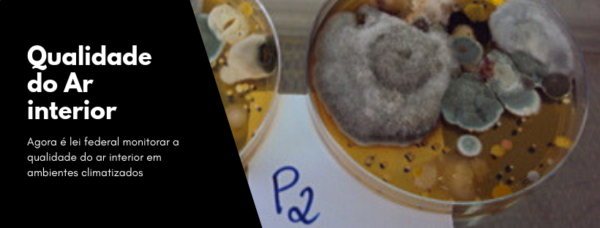

BLOG TECMA
Resolução no 9, de 16 de janeiro de 2003, ANVISA virou Lei federal.
O PRESIDENTE DA REPÚBLICA Faço saber que o Congresso Nacional decreta e eu sanciono a seguinte Lei: Art. 1o Todos [...]
Gandhi Giordano lança livro sobre Estudos de Tratabilidade
Os efluentes Industriais apresentam características muito distintas, sua rota tecnológica é definida sempre por um estudo de tratabilidade. Importantes [...]
Load More Posts